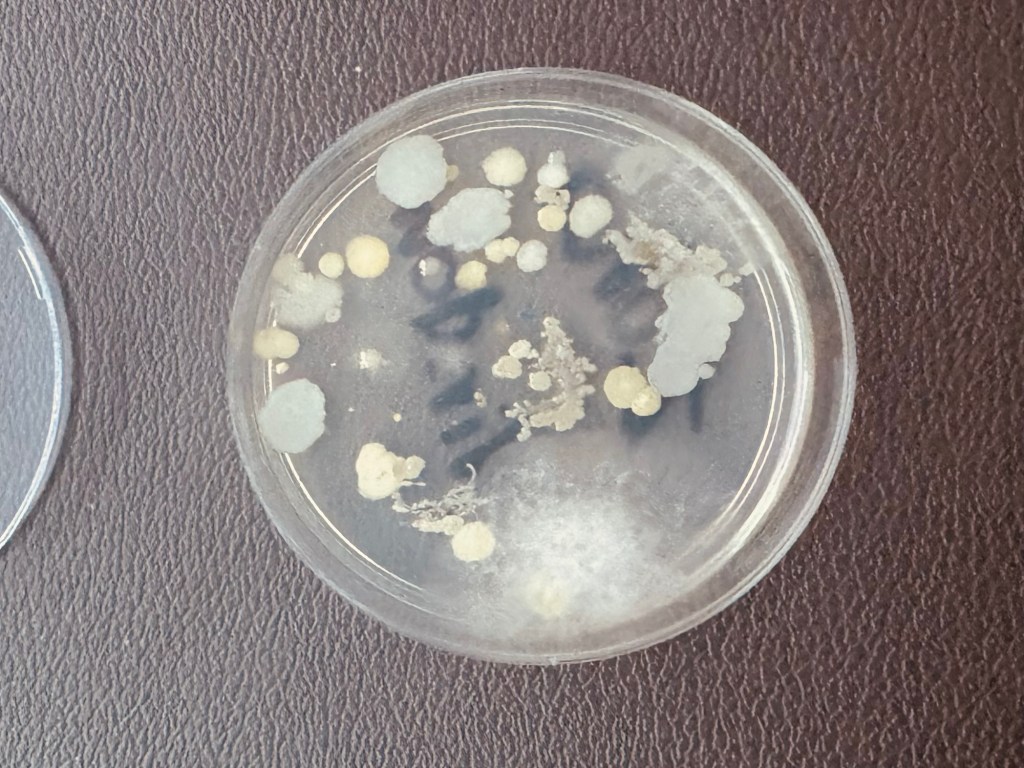
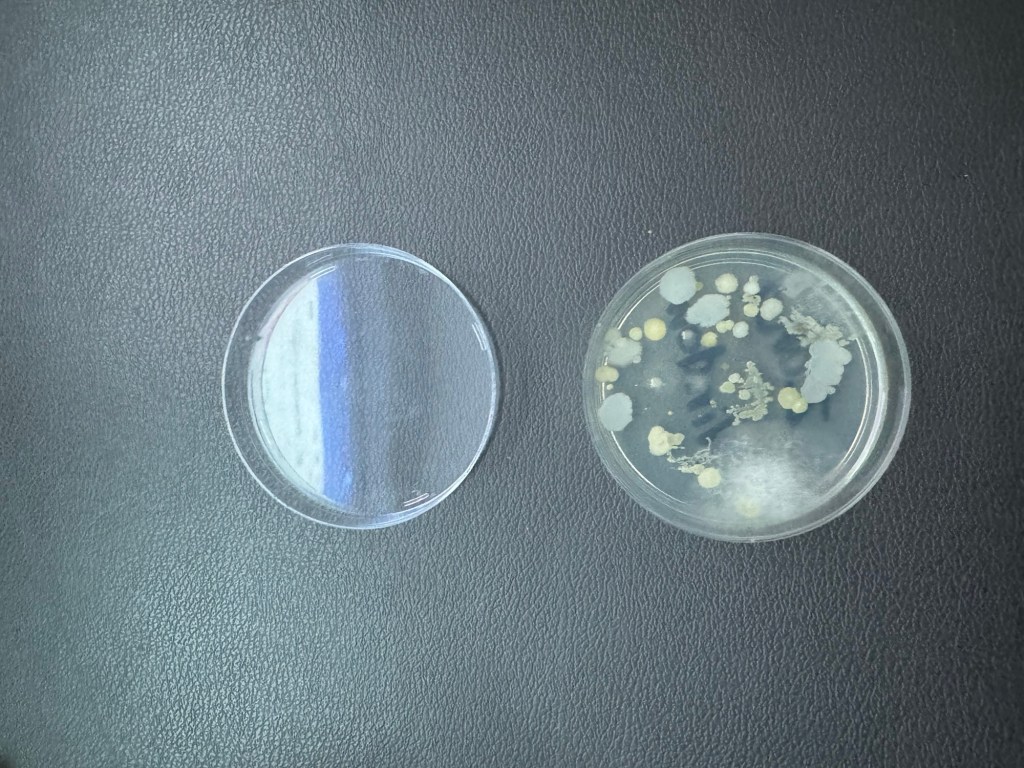
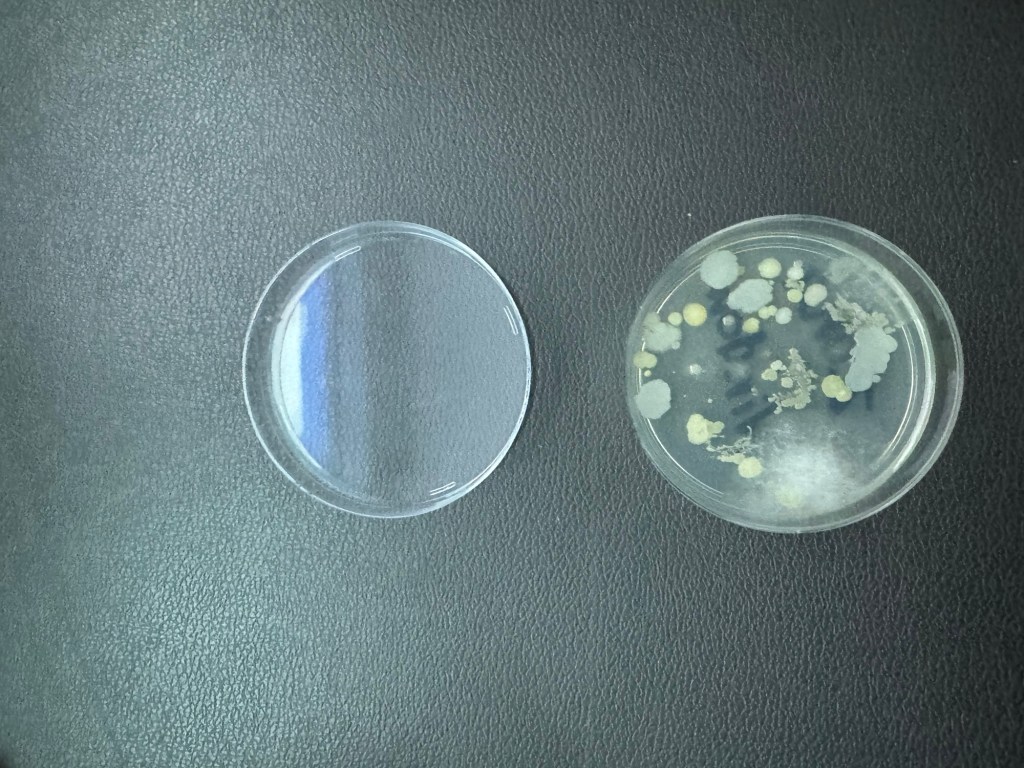
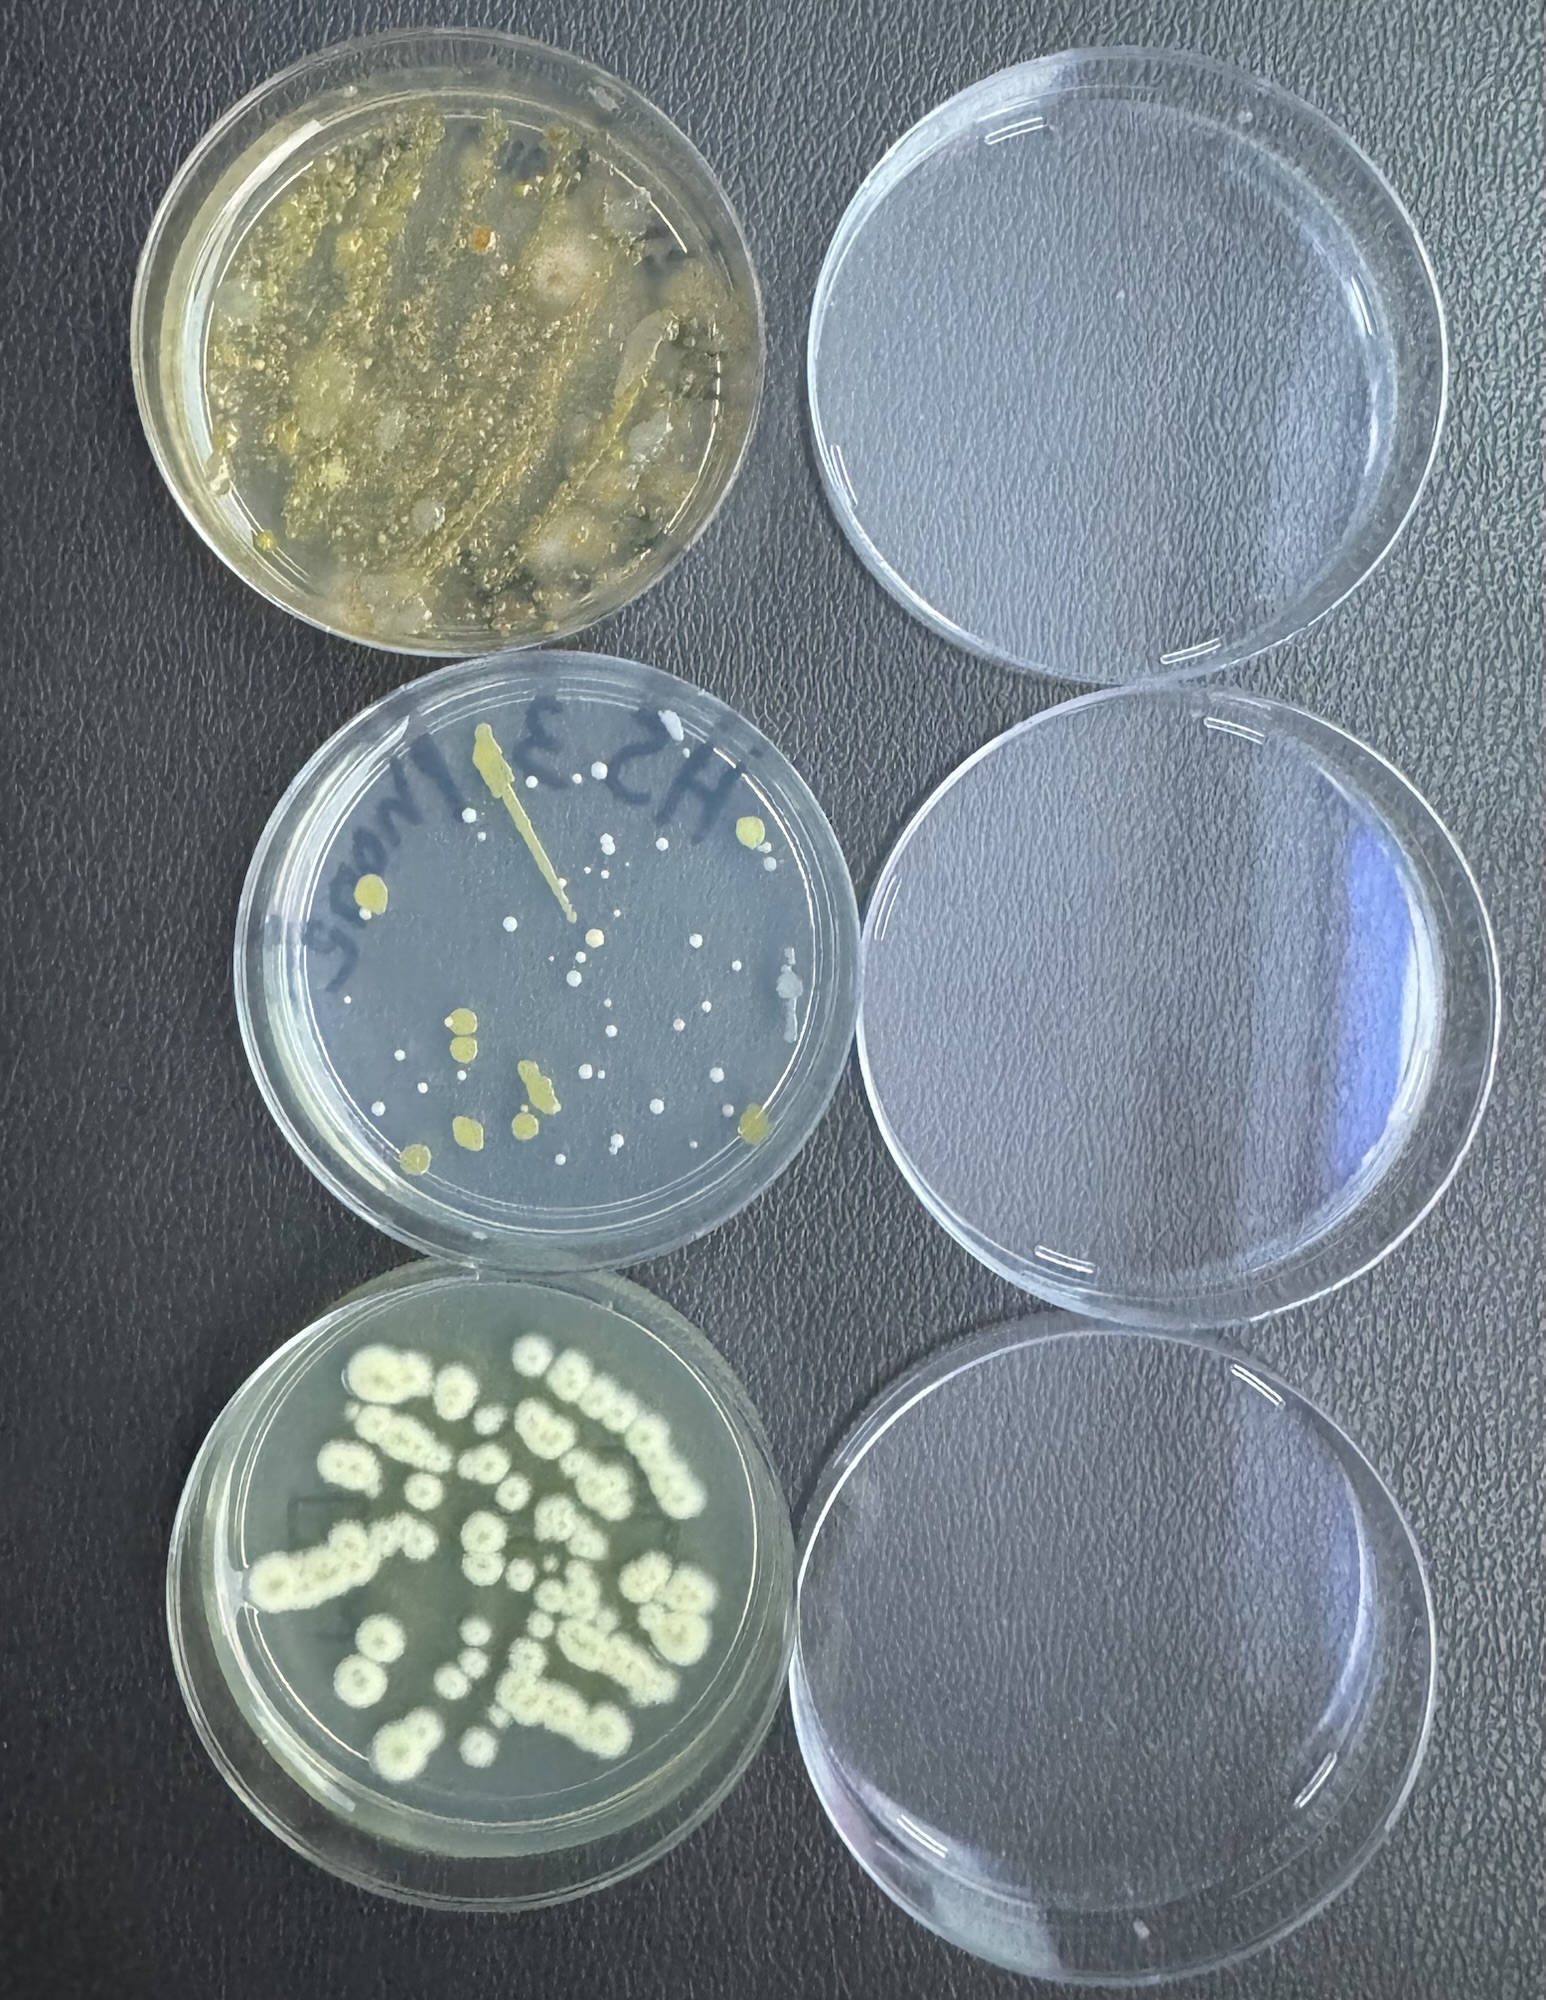
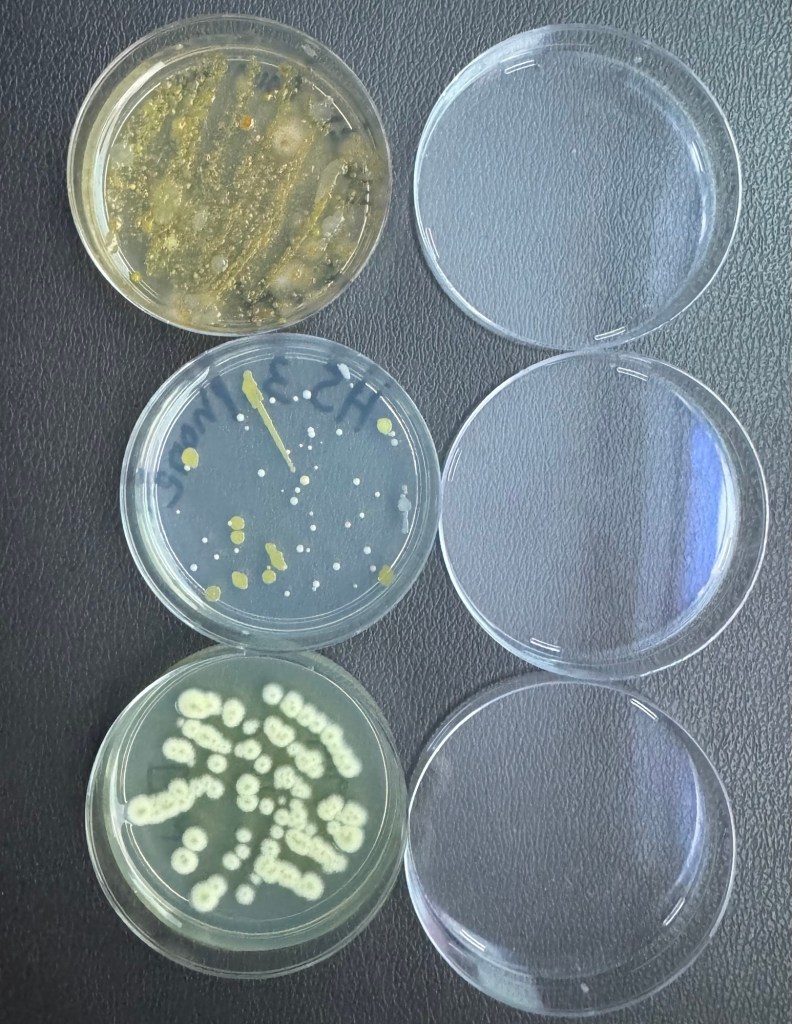
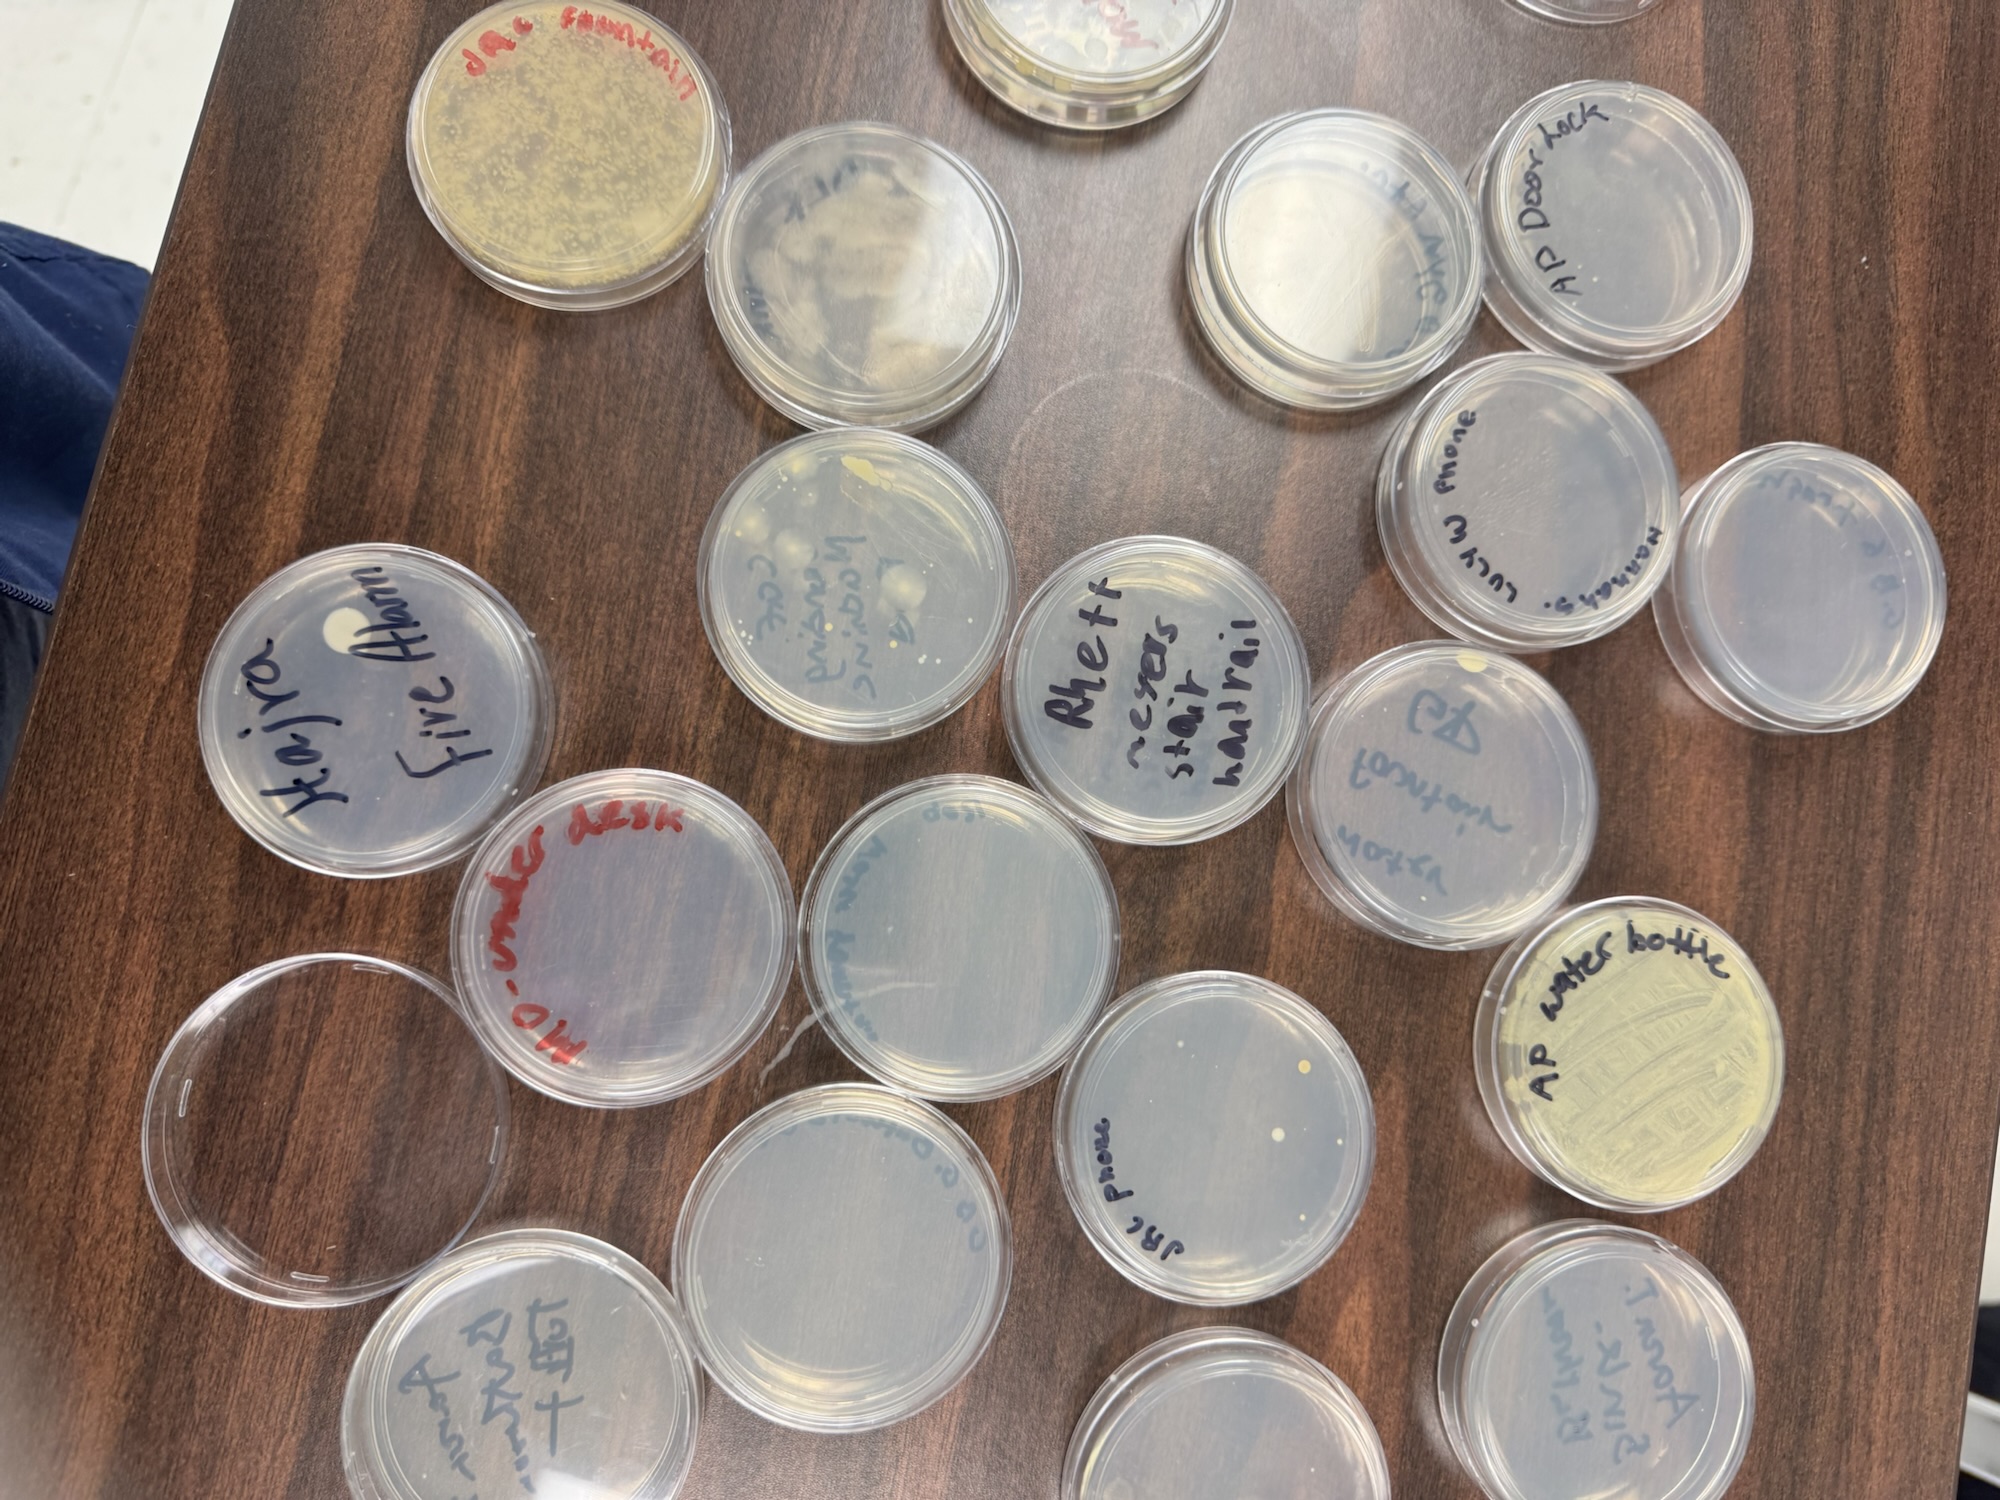
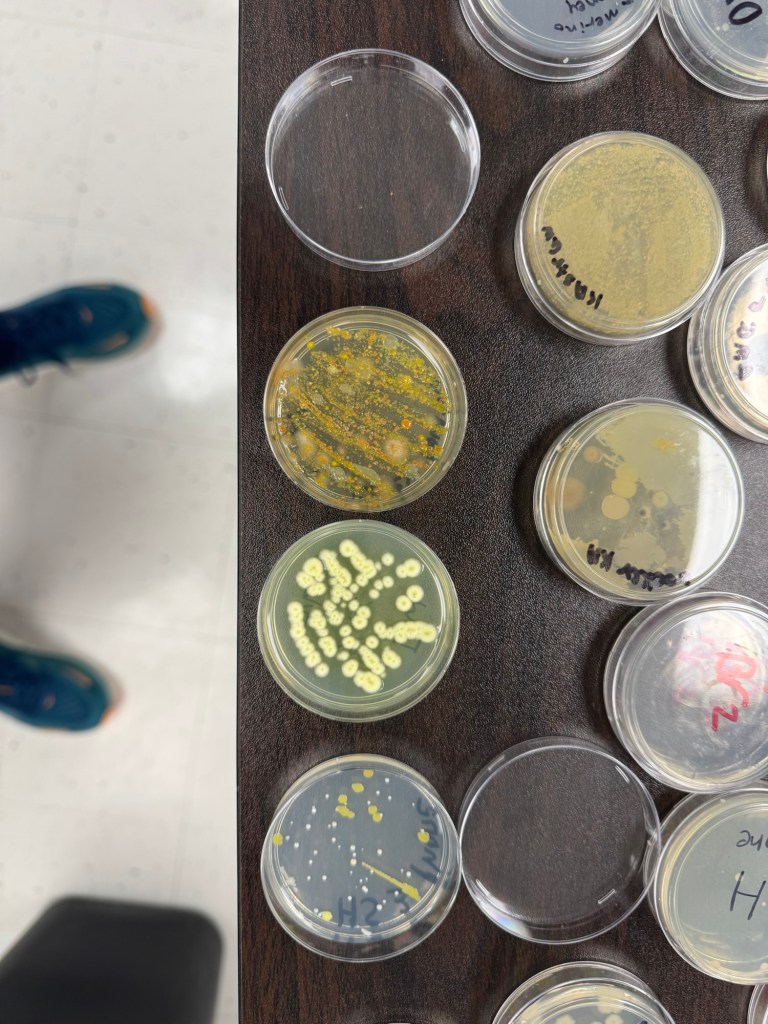
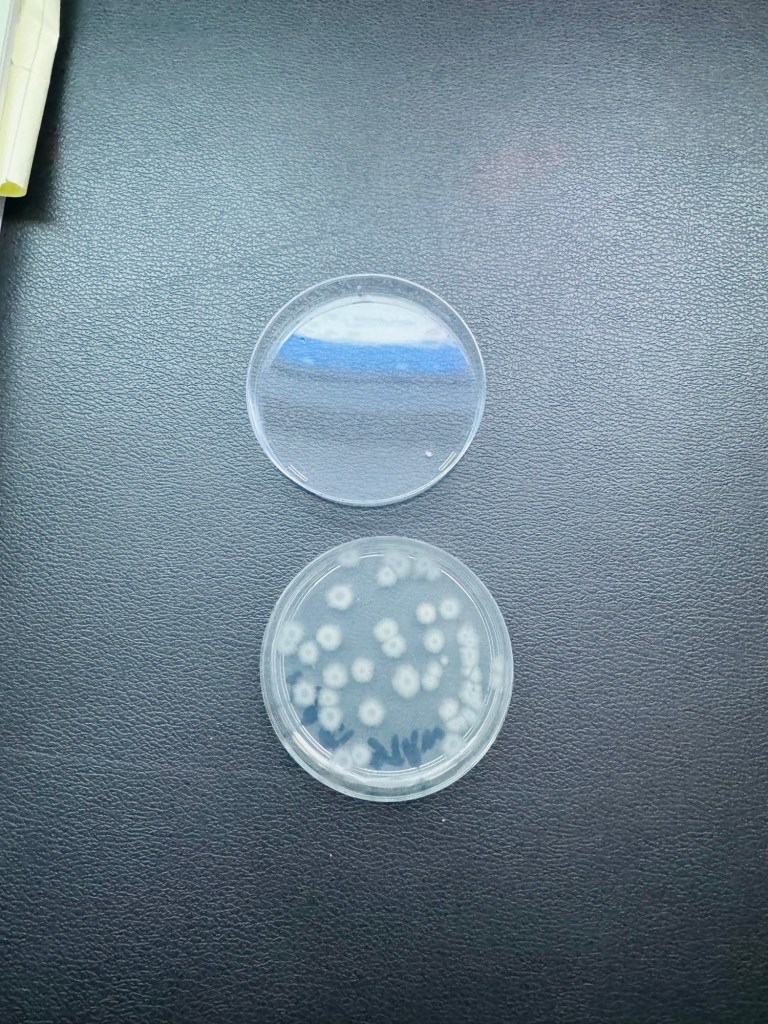
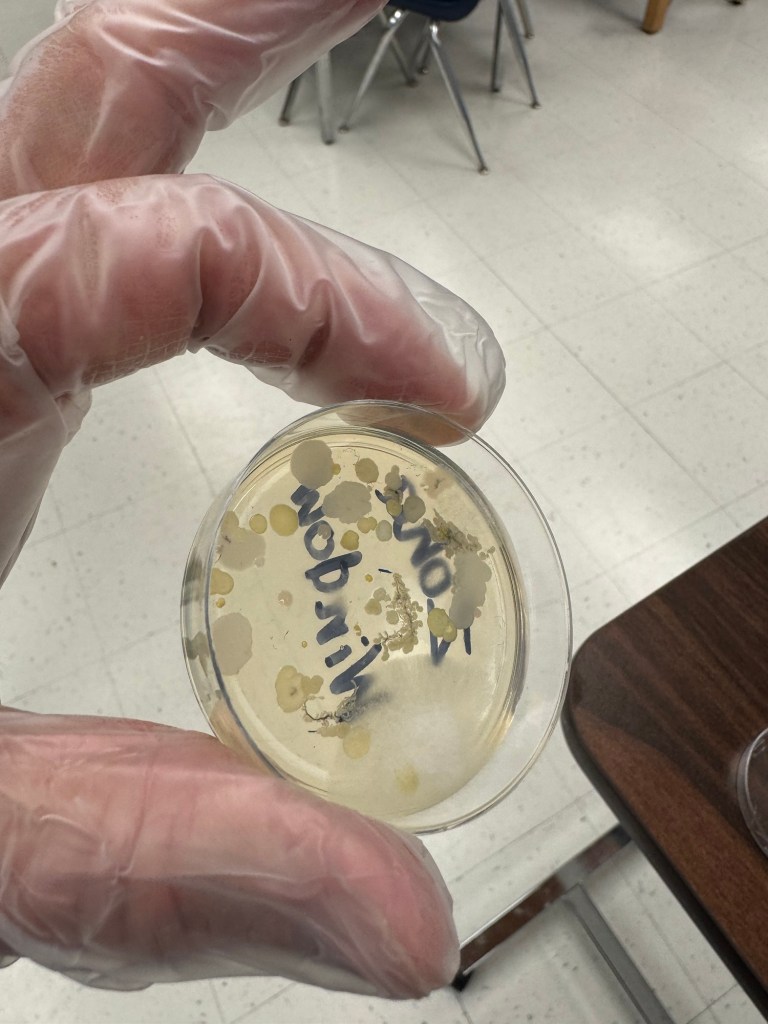
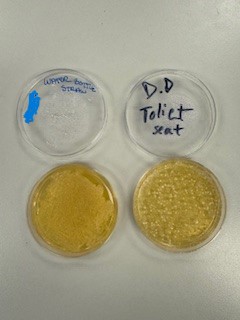

School hasn’t even started yet and I’m making a post. The emails from the principal and my administrator are coming fast and furious. Medical Assistant is in the second year of it being a two year course. MAI is for juniors and MAII is for seniors who were in my class last year and chose to continue and work toward certification. I have equipment and supplies waiting for us to use for lots of hands-on activities such as injections, venipuncture, eye exams, and EKGs.
Juniors will again have the opportunity to assist with hearing and vision exams at area middle and high schools with seniors acting in a supervisory role. Seniors will be able to do an externship, I hope, with the Inova Health System. This will be a valuable experience as well as look good on a resume.
I’m looking forward to another exciting year in Biotechnology Foundations. We are once again planning on a field trip to a processing lab at Inova. They put on an awesome event for us last year. I have the supplies ready for our first lab which I always do within days of school starting. And as always, we will learn a little, laugh a lot, and gain skills with biotechnology equipment.
Looking forward to seeing you all soon.
RM